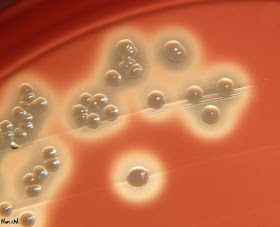

With Lumify, high-quality ultrasound is available almost anywhere. Just subscribe, download the Lumify app, plug in the transducer, and you're set. Meet patients at the point-of-care, get a faster diagnosis, and deliver care whenever it's needed.
Read more:
Lumify | Ultrasound Imaging
Source: Phillips
Art and Science of Laboratory Medicine. Clinical laboratory and biomedical science related news, abstracts and images for medical laboratory professionals, students and other laboratory geeks.
Sunday, January 31, 2016
Preanalytical Nightmare
Very innovative solution to take a sample for HbA1c
Source Facebook
Image credits: Emilie Dubé Blaquière
Source Facebook
Image credits: Emilie Dubé Blaquière
Sunday Gram Stain Challenge
CSF gram stain
Case: Four years old girl from Coban, Guatemala is crying a lot. She has high fewer and she is complaining about headace. Basic blood tests were taken in the local healthcare center. CRP and leukocytes were slightly elevated and Hb within the normal limits. Family was sent to the central hospital and CSF sample was taken of the patient. Findings are in the image below.
What are the findings of this CSF gram stain?
Correct answer is below the image.
(Click image to enlarge)
.
Correct answer: Gram negative coccobacilli 3+ (H. influenzae) and leukocytes 3+
Case: Four years old girl from Coban, Guatemala is crying a lot. She has high fewer and she is complaining about headace. Basic blood tests were taken in the local healthcare center. CRP and leukocytes were slightly elevated and Hb within the normal limits. Family was sent to the central hospital and CSF sample was taken of the patient. Findings are in the image below.
What are the findings of this CSF gram stain?
Correct answer is below the image.
(Click image to enlarge)
.Correct answer: Gram negative coccobacilli 3+ (H. influenzae) and leukocytes 3+
Introduction to Flow Cytometry
Flow cytometry is a laser-based, biophysical technology employed in cell counting, cell sorting, biomarker detection and protein engineering, by suspending cells in a stream of fluid and passing them by an electronic detection apparatus. It allows simultaneous multiparametric analysis of the physical and chemical characteristics of up to thousands of particles per second.
Flow cytometry is routinely used in the diagnosis of health disorders, especially blood cancers, but has many other applications in basic research, clinical practice and clinical trials. A common variation is to physically sort particles based on their properties, so as to purify populations of interest.
This tutorial on flow cytometry looks at the systems that make up the flow cytometer and how those systems work together to collect information on cells as they pass through a laser when two or more fluorescent colors are used.
Read more:
Molecular Probes Tutorial Series—Introduction to Flow Cytometry
Source: YouTube via Thermo Fisher
Flow cytometry is routinely used in the diagnosis of health disorders, especially blood cancers, but has many other applications in basic research, clinical practice and clinical trials. A common variation is to physically sort particles based on their properties, so as to purify populations of interest.
This tutorial on flow cytometry looks at the systems that make up the flow cytometer and how those systems work together to collect information on cells as they pass through a laser when two or more fluorescent colors are used.
Read more:
Molecular Probes Tutorial Series—Introduction to Flow Cytometry
Source: YouTube via Thermo Fisher
New insights into Group A Streptococcus
The ability of Group A Streptococcus (GAS) to induce rapid destruction of red blood cells has been observed for more than a century and remains a clinical hallmark of GAS diagnosis. This destruction is due to the production of a small peptide toxin by GAS known as Streptolysin S (SLS).
Although it has been widely held that SLS exerts its lytic activity -- the excessive destruction of red blood cells -- through membrane disruption, its exact mode of action has remained unknown.
Findings critical to the support of our hypothesis were provided by in vivo studies performed at the W.M. Keck Center for Transgene Research, under the direction of Francis Castellino and Victoria Ploplis. Using humanized mouse models, Keck scientists Deborah Donahue and Jeff Mayfield demonstrated that by blocking the action of SLS toxin during a GAS infection, the pathology at the site of the infection could be drastically reduced. These findings have tremendous potential for developing novel therapeutics to treat severe diseases caused by Group A Streptococcus.
Read more:
Study offers new insights into Group A Streptococcus | EurekAlert! Science News
Source: EurekAlert! Science News
Image credits: Bacteria in photos
Although it has been widely held that SLS exerts its lytic activity -- the excessive destruction of red blood cells -- through membrane disruption, its exact mode of action has remained unknown.
Findings critical to the support of our hypothesis were provided by in vivo studies performed at the W.M. Keck Center for Transgene Research, under the direction of Francis Castellino and Victoria Ploplis. Using humanized mouse models, Keck scientists Deborah Donahue and Jeff Mayfield demonstrated that by blocking the action of SLS toxin during a GAS infection, the pathology at the site of the infection could be drastically reduced. These findings have tremendous potential for developing novel therapeutics to treat severe diseases caused by Group A Streptococcus.
Read more:
Study offers new insights into Group A Streptococcus | EurekAlert! Science News
Source: EurekAlert! Science News
Image credits: Bacteria in photos
Saturday, January 30, 2016
HbA1c as an indicator of Diabetes Control
The term HbA1c refers to glycated haemoglobin. It develops when haemoglobin, a protein within red blood cells that carries oxygen throughout your body, joins with glucose in the blood, becoming glycated. By measuring glycated haemoglobin (HbA1c), clinicians are able to get an overall picture of what our average blood sugar levels have been over a period of weeks/months.
For people with diabetes this is important as the higher the HbA1c, the greater the risk of developing diabetes-related complications. HbA1c is also referred to as haemoglobin A1c or simply A1c.
Read more:
What is HbA1c? - Definition, Units, Conversion, Testing & Control
Source: Diabetes.co.uk
For people with diabetes this is important as the higher the HbA1c, the greater the risk of developing diabetes-related complications. HbA1c is also referred to as haemoglobin A1c or simply A1c.
Read more:
What is HbA1c? - Definition, Units, Conversion, Testing & Control
Source: Diabetes.co.uk
Important work behind the scenes
The hidden profession that saves lives
Medical Laboratory Science (also called Clinical Laboratory Science or Biomedical Laboratory Science) is one of the most under-recognized health professions.
We are proud of our work and we shall show it to the world.
Image credits: Lisa Edwards
Medical Laboratory Science (also called Clinical Laboratory Science or Biomedical Laboratory Science) is one of the most under-recognized health professions.
We are proud of our work and we shall show it to the world.
Image credits: Lisa Edwards
Healthy Fat-Rich Diet Improve Women LDL and HDL levels
Overweight and obese adult women were enrolled in a one-year behavioral weight loss program and randomly assigned to one of three diets consisting of either: low-fat and high-carbohydrate; low-carbohydrate and high-fat; or a walnut-rich, high-fat and low-carbohydrate diet.
The findings showed that all three dietary plans promoted similar weight loss. Insulin-sensitive women lost the most weight with a low-fat diet but that strategy did not result in the most benefit for lipid levels.
The walnut-rich diet had the most impact on cholesterol levels by decreasing low-density lipoprotein (LDL), or bad cholesterol, and increasing beneficial high-density lipoprotein (HDL). The high-fat, low-carb group, which consumed monounsaturated fats, did not experience the same beneficial effects as the walnut-rich diet, which featured polyunsaturated fatty acids.
At six months, the average weight loss was almost 8 percent among all groups.
Read more:
Cholesterol Levels Improve with Weight Loss and Healthy Fat-Rich Diet
Source: UC San Diago Health
The findings showed that all three dietary plans promoted similar weight loss. Insulin-sensitive women lost the most weight with a low-fat diet but that strategy did not result in the most benefit for lipid levels.
The walnut-rich diet had the most impact on cholesterol levels by decreasing low-density lipoprotein (LDL), or bad cholesterol, and increasing beneficial high-density lipoprotein (HDL). The high-fat, low-carb group, which consumed monounsaturated fats, did not experience the same beneficial effects as the walnut-rich diet, which featured polyunsaturated fatty acids.
At six months, the average weight loss was almost 8 percent among all groups.
Read more:
Cholesterol Levels Improve with Weight Loss and Healthy Fat-Rich Diet
Source: UC San Diago HealthImproving Real-Time PCR Data Quality
The polymerase chain reaction (PCR) has radically transformed biological science, allowing sophisticated analysis of genes and the genome. Revolutionizing the study of DNA, PCR is often hailed as one of the most important scientific advances of the 20th century. Over time, PCR has evolved into fluorescence-based quantitative real-time PCR (qPCR), which is now considered the molecular diagnostic technique of choice due to its capacity to detect and measure minute amounts of nucleic acids in a variety of samples from multiple sources.
Due to its practical simplicity, in combination with its outstanding capabilities, including speed, sensitivity, and specificity, qPCR plays a huge role in a number of applications, among them gene expression analysis, microRNA analysis, single nucleotide polymorphism genotyping, copy number variation analysis, and protein analysis.
The success and reputation of qPCR is reflected in the abundance of publications reporting qPCR data. Despite substantial advances in the accessibility and ease-of-use of qPCR for diagnostics, generating an assay that is capable of delivering reliable, reproducible, and meaningful results is still a challenging task.
Read more:
Improving Real-Time PCR Data Quality
Source: GEN Magazine Articles
Due to its practical simplicity, in combination with its outstanding capabilities, including speed, sensitivity, and specificity, qPCR plays a huge role in a number of applications, among them gene expression analysis, microRNA analysis, single nucleotide polymorphism genotyping, copy number variation analysis, and protein analysis.
The success and reputation of qPCR is reflected in the abundance of publications reporting qPCR data. Despite substantial advances in the accessibility and ease-of-use of qPCR for diagnostics, generating an assay that is capable of delivering reliable, reproducible, and meaningful results is still a challenging task.
Read more:
Improving Real-Time PCR Data Quality
Source: GEN Magazine Articles
Friday, January 29, 2016
Blood Clot
Amazing image of blood clot.
Read more:
Scinerds: Blood Clot NIH: National Heart, Lung,...
Source: Tumblr via Scientific Illustration
Read more:
Scinerds: Blood Clot NIH: National Heart, Lung,...
Source: Tumblr via Scientific Illustration
This Lego Microscope Actually Works
This working Lego microscope was built by Carl Merriman. It's sleek, functional and even though you couldn't use it to study Ebola or the T-Virus, it's still a pretty sweet piece of kit.
This build was originally inspired by the LEGO X-Pod sets. While trying to find a use for the pod itself, I realized that it was very close to a deep petri dish. I used a planetary gear system to allow both coarse and fine adjustment of the objective “lens”. A little more tinkering and I connected the focus to a magnifying glass and fiber optic light in the eyepiece, so adjusting the focus knobs would actually bring the writing on a LEGO stud in and out of focus.
Read more:
This Lego Microscope Actually Works
Source: Like cool
This build was originally inspired by the LEGO X-Pod sets. While trying to find a use for the pod itself, I realized that it was very close to a deep petri dish. I used a planetary gear system to allow both coarse and fine adjustment of the objective “lens”. A little more tinkering and I connected the focus to a magnifying glass and fiber optic light in the eyepiece, so adjusting the focus knobs would actually bring the writing on a LEGO stud in and out of focus.
Read more:
This Lego Microscope Actually Works
Source: Like cool
Increased Baseline CRP is Associated with Increased Risk of Infections
The acute-phase reactant C-reactive protein (CRP) increases rapidly during an infection. We tested the hypothesis that chronic low-level increases in CRP are associated with an increased risk of infectious disease.
Individuals with CRP >3 mg/L had 1.2 and 1.7 times increased risk of infectious disease, in the prospective general population cohort and the cross-sectional general population study, respectively, compared with individuals with CRP <1 mg/L. In the combined populations, individuals in the highest CRP tertile (compared with the lowest) had an increased risk of bacterial diseases (hazard ratio 1.7, 95% CI 1.6–1.8), but not viral, mycosis, and parasitic diseases. The increased risk was mainly carried by pneumonia, sepsis, and particularly gram-negative infections. None of the genotype combinations examined conferred an increased risk of infectious disease.
Chronic low-level CRP increases were associated with increased risk of bacterial infections, gram-negative infections in particular. Genotypes associated with increases in CRP were not associated with increased risk of infection.
Read more:
Increased Baseline C-Reactive Protein Concentrations Are Associated with Increased Risk of Infections: Results from 2 Large Danish Population Cohorts
Source: Clinical Chemistry
Individuals with CRP >3 mg/L had 1.2 and 1.7 times increased risk of infectious disease, in the prospective general population cohort and the cross-sectional general population study, respectively, compared with individuals with CRP <1 mg/L. In the combined populations, individuals in the highest CRP tertile (compared with the lowest) had an increased risk of bacterial diseases (hazard ratio 1.7, 95% CI 1.6–1.8), but not viral, mycosis, and parasitic diseases. The increased risk was mainly carried by pneumonia, sepsis, and particularly gram-negative infections. None of the genotype combinations examined conferred an increased risk of infectious disease.
Chronic low-level CRP increases were associated with increased risk of bacterial infections, gram-negative infections in particular. Genotypes associated with increases in CRP were not associated with increased risk of infection.
Read more:
Increased Baseline C-Reactive Protein Concentrations Are Associated with Increased Risk of Infections: Results from 2 Large Danish Population Cohorts
Source: Clinical Chemistry
Thursday, January 28, 2016
Zika Virus Update
Zika virus is a mosquito-borne flavivirus transmitted primarily by Aedes aegypti mosquitoes. Zika virus was incidentally discovered in Uganda in 1947 during mosquito and primate surveillance. It was named for the forest in Uganda where it was first discovered. Until recently Zika virus remained confined to a few countries in across Africa and into Asia and circulated predominantly in wild primates and Aedes africanus mosquitos. Human infections were rare.
More recently, Zika virus has spread from Africa into several countries in Latin America along with the Aedes aegypti mosquito. Brazilian officials estimate that between 440,000 and 1,300,000 cases have occurred in 2015. In 2016, Zika virus transmission has been reported in 19 other countries or territories in the Americas. Western Hemisphere countries and territories include Colombia, El Salvador, French Guiana, Guatemala, Haiti, Honduras, Martinique, Mexico, Panama, Puerto Rico, Paraguay, Suriname and Venezuela.
Read more:
Zika Virus Update
Source: ClinLab Navigator
Image credits: CDC
More recently, Zika virus has spread from Africa into several countries in Latin America along with the Aedes aegypti mosquito. Brazilian officials estimate that between 440,000 and 1,300,000 cases have occurred in 2015. In 2016, Zika virus transmission has been reported in 19 other countries or territories in the Americas. Western Hemisphere countries and territories include Colombia, El Salvador, French Guiana, Guatemala, Haiti, Honduras, Martinique, Mexico, Panama, Puerto Rico, Paraguay, Suriname and Venezuela.
Read more:
Zika Virus Update
Source: ClinLab Navigator
Image credits: CDC
Wednesday, January 27, 2016
Periodic Table Panel Dress
What's your fashion element? Shake up your wardrobe with this chemistry chic dress, inspired by Yves Saint Laurent's famous "Mondrian Dress".
Read more:
Periodic Table Panel Dress
Source: Shenova
Read more:
Periodic Table Panel Dress
Source: Shenova
Scientists discover new antibiotic from breast milk
Scientists have developed a new antibiotic from human breast milk. The British team from London's National Physical Laboratory have developed the new drug which can wipe out drug-resistant bacteria, it is claimed. The protein, called lactoferrin, effectively kills bacteria, fungi and even viruses on contact.
The breakthrough, by the National Physical Laboratory (NPL) and University College London, found that the minuscule fragment, less than a nanometre in width, is responsible for giving the protein its anti-microbial properties. This is what makes breast milk so important in protecting infants from disease in their first months of life. The protein, called lactoferrin, effectively kills bacteria, fungi and even viruses on contact. After identifying the fragment, scientists re-engineered it into a virus-like capsule that can recognise and target specific bacteria and damage them on contact, but without affecting any surrounding human cells.
Read more.
Scientists discover new antibiotic from breast milk
Source: The Quardian
The breakthrough, by the National Physical Laboratory (NPL) and University College London, found that the minuscule fragment, less than a nanometre in width, is responsible for giving the protein its anti-microbial properties. This is what makes breast milk so important in protecting infants from disease in their first months of life. The protein, called lactoferrin, effectively kills bacteria, fungi and even viruses on contact. After identifying the fragment, scientists re-engineered it into a virus-like capsule that can recognise and target specific bacteria and damage them on contact, but without affecting any surrounding human cells.
Read more.
Scientists discover new antibiotic from breast milk
Source: The Quardian
Tuesday, January 26, 2016
Chemistry Girl
Nekrasov Tale of chemistry
Itkina Illustrations A. and N. Rozhnova.
M, Little, 1965
16str., 22H28 cm
Read more:
Whistling in the Dark
Source: Tumblr by Whistling in the Dark
Itkina Illustrations A. and N. Rozhnova.
M, Little, 1965
16str., 22H28 cm
Read more:
Whistling in the Dark
Source: Tumblr by Whistling in the Dark
Rota-Rack for MicroTubes
Rotate each of the four modules independently. Use several sizes of test tubes, culture tubes, centrifuge tubes, or microcentrifuge tubes at the same time. Click each module into place, load with tubes and carry. Rack maintains its orientation until you twist it again. Comes fully assembled. Autoclavable. Each module of the Rota-Rack for large tubes holds two 50 mL tubes, eight 15 mL tubes, six 20 mm tubes, or ten 10-13 mm tubes. Each module of the Rota-Rack for microtubes holds six 15 mL tubes, nine 1.5/2.0 mL tubes, twelve 0.5/0.6 mL tubes, or thirty-two 0.2 mL PCR tubes or four 8-tube strips. Measures 210mm length by 100mm width by 100mm height.
Read more:
Heathrow Scientific HD29040B Rota-Rack Rotating 4-WAY Tube Rack for MicroTubes
Source: Amazon by Heathrow Scientific
Read more:
Heathrow Scientific HD29040B Rota-Rack Rotating 4-WAY Tube Rack for MicroTubes
Source: Amazon by Heathrow Scientific
Full set for Biomedical Scientists - Linha Competa Biomedicina
Beautiful set of jewellry for biomedical laborattory scientists.
Iconosquare by Sollara Folheados
Read more:
Linha competa BIOMEDICINA
Iconosquare by Sollara Folheados
Read more:
Linha competa BIOMEDICINA
New Tests for Zika Virus
As reports of Zika virus infections continue to spread through the Americas, countless questions loom. Chief among them is about the relationship between infection during pregnancy and microcephaly in babies, which has been difficult to pin down given the limitations of current diagnostics. A number of researchers are working at breakneck speed to develop immunological reagents and assays that could confirm whether a person has had a Zika infection.
Currently, the standard assay for Zika viral infection is a PCR test that probes for the presence of viral RNA in a sample.
More user-friendly serologic tests, which measure the presence of antibodies against a particular pathogen, would be a better alternative, but in the case of Zika it’s been difficult to tell which flavivirus a person has encountered—whether dengue, Zika, or another. “And the problem is, where Zika is occurring is the same place dengue is occurring,” said immunobiologist Mike Diamond of Washington University in St. Louis.
Several commercial outfits are selling serologic Zika tests. For instance, San Diego–based MyBioSource sells an IgM ELISA to test for Zika. Biocan Diagnostics, based in Canada, is selling a finger-prick assay that can detect IgM and IgG antibodies (which are elevated even longer after an infection than IgM antibodies) against Zika and give results in five to 10 minutes. “It can be used in field settings or mobile clinics, and doesn’t need any special equipment,” said Bhavjit Jauhar, the vice president of sales and development for Biocan. He said his firm’s screening test is 99 percent specific, with no cross-reactivity with dengue or chikungunya.
Read more:
New Tests for Zika in the Works
Source: TheScientist Magazine
Currently, the standard assay for Zika viral infection is a PCR test that probes for the presence of viral RNA in a sample.
More user-friendly serologic tests, which measure the presence of antibodies against a particular pathogen, would be a better alternative, but in the case of Zika it’s been difficult to tell which flavivirus a person has encountered—whether dengue, Zika, or another. “And the problem is, where Zika is occurring is the same place dengue is occurring,” said immunobiologist Mike Diamond of Washington University in St. Louis.
Several commercial outfits are selling serologic Zika tests. For instance, San Diego–based MyBioSource sells an IgM ELISA to test for Zika. Biocan Diagnostics, based in Canada, is selling a finger-prick assay that can detect IgM and IgG antibodies (which are elevated even longer after an infection than IgM antibodies) against Zika and give results in five to 10 minutes. “It can be used in field settings or mobile clinics, and doesn’t need any special equipment,” said Bhavjit Jauhar, the vice president of sales and development for Biocan. He said his firm’s screening test is 99 percent specific, with no cross-reactivity with dengue or chikungunya.
Read more:
New Tests for Zika in the Works
Source: TheScientist MagazineMonday, January 25, 2016
Good morning laboratorians
Hematology mug for coffee breaks of laboratory professionals
Hematology it's a blast!
Surprise that super lab professional in your life with this uniquely designed gift!
Read more
Mug CP121286767
Source: Cafe press
Hematology it's a blast!
Surprise that super lab professional in your life with this uniquely designed gift!
Read more
Mug CP121286767
Source: Cafe press
Sunday, January 24, 2016
Love effects at the cellular level
When you are in love, every single cell in your body knows it
Source: Facebook
Image credits: ines salina
Source: Facebook
Image credits: ines salina
Sunday Blood Cell Challenge
Peripheral blood cell morphology quiz
Case: 52 years old shop keepr from Rotterdam has high fever and bruices in her legs and arms. She has been very weak and lost her appetite a week ago. She went to the primary healthcare center and basic blood test were taken. CRP was 35 mg/L, Hb 104 g/L and leukocytes 18.2 x10 9/L. Peripheral blood smear was sent to central lab and the typical findings are in the image below.
Can you identify these three cells (A, B and C)?
Correct anser is below the image.
(Click image to enlarge)
.
Correct answer: All three cells are lymphocytes. A: Plasmacytoid lymphocyte, B: Malignant lymphocyte with crystalline inclusion, C: Reactive lymphocyte.
Case: 52 years old shop keepr from Rotterdam has high fever and bruices in her legs and arms. She has been very weak and lost her appetite a week ago. She went to the primary healthcare center and basic blood test were taken. CRP was 35 mg/L, Hb 104 g/L and leukocytes 18.2 x10 9/L. Peripheral blood smear was sent to central lab and the typical findings are in the image below.
Can you identify these three cells (A, B and C)?
Correct anser is below the image.
(Click image to enlarge)
.
Correct answer: All three cells are lymphocytes. A: Plasmacytoid lymphocyte, B: Malignant lymphocyte with crystalline inclusion, C: Reactive lymphocyte.
APOBEC, a defense protein that causes cancer
Cancer is caused by the growth of an abnormal cell which harbours DNA mutations, "copy errors" occurring during the DNA replication process. If these errors do take place quite regularly without having any damaging effect on the organism, some of them affect a specific part of the genome and cause the proliferation of the mutant cell, which then invades the organism. A few years ago, scientists have identified an important mutagen which lies in our own cells: APOBEC, a protein that usually functions as protecting agent against viral infection. Today, a team of Swiss and Russian scientists led by Sergey Nikolaev, geneticist at the University of Geneva (UNIGE), Switzerland, has deciphered how APOBEC takes advantage of a weakness in our DNA replication process to induce mutations in our genome. To be read in Genome Research.
Read more:
A defense protein that causes cancer
Read more: EurekAlert! Science News
Read more:
A defense protein that causes cancer
Read more: EurekAlert! Science News
Saturday, January 23, 2016
Scientists use protein-blocker to stop the spread of leukaemia
Acute myeloid leukaemia (AML) is one of the most aggressive and damaging types of cancer there is: it appears without much warning and the five-year survival rate for sufferers is just 24 percent. However, improved treatments could soon be on the way, as researchers from the Walter and Eliza Hall Institute in Melbourne, Australia have identified a protein that's crucial to the spread of the blood cancer.
The protein in question is called the Hhex protein, and by cutting off its production, the team has shown the cancer can be stopped in its tracks - in laboratory conditions, at least. The next step is to see whether the same 'handbrake' mechanism would work in humans, but the initial signs are promising.
Read more:
Scientists use protein-blocker to stop the spread of leukaemia
Source: ScienceAlert
The protein in question is called the Hhex protein, and by cutting off its production, the team has shown the cancer can be stopped in its tracks - in laboratory conditions, at least. The next step is to see whether the same 'handbrake' mechanism would work in humans, but the initial signs are promising.
Read more:
Scientists use protein-blocker to stop the spread of leukaemia
Source: ScienceAlert
Biologists Develop Method for Antibiotic Susceptibility Testing
The UC San Diego biologists say their new method has the potential to be applied to many different types of bacteria. “Our new method worked surprising well at rapidly detecting antibiotic resistant strains of S. aureus,” said Diana Quach, a graduate student and lead author on the study. “We are now optimizing it to provide a more accurate test for other types of antibiotic resistant bacteria, such as Pseudomonas aeruginosa.”
Examining single cells has two key advantages over other testing methods, say the researchers. First, it is rapid, cutting days off the time for typical culture-based assays. It often takes days for a doctor to receive information on resistance, and this means that patients with life-threatening infections are often treated with the assumption that the infection is drug-resistant. Second, this method does not rely on having any detailed understanding of the bacterium causing the infection, or of the genes that convey resistance. This is particularly important in this case, since resistance to the drugs used to treat MRSA infections arise by several evolutionary pathways via different combinations of mutations, and it could also provide rapid treatment information for newly emerging bacterial pathogens, such as that which caused the infections transmitted by endoscopes.
Read more:
Biologists Develop Method for Antibiotic Susceptibility Testing
Source: US San Diago
Examining single cells has two key advantages over other testing methods, say the researchers. First, it is rapid, cutting days off the time for typical culture-based assays. It often takes days for a doctor to receive information on resistance, and this means that patients with life-threatening infections are often treated with the assumption that the infection is drug-resistant. Second, this method does not rely on having any detailed understanding of the bacterium causing the infection, or of the genes that convey resistance. This is particularly important in this case, since resistance to the drugs used to treat MRSA infections arise by several evolutionary pathways via different combinations of mutations, and it could also provide rapid treatment information for newly emerging bacterial pathogens, such as that which caused the infections transmitted by endoscopes.
Read more:
Biologists Develop Method for Antibiotic Susceptibility Testing
Source: US San Diago
New discovery: Malaria parasite is dependent on heavy metals
The malaria parasite is rendered barren when the transport of heavy metals such as copper and iron is blocked. This is the conclusion reached by malaria researcher Taco Kooij and international colleagues in a study published today in Nature Communications. In addition, the researchers identified six proteins that are essential to the life stages of the parasite in which it sickens its host. They also discovered a gene that is essential for the parasite to settle in its host. This study provides clues for new malaria drugs and vaccines.
The important finding is that the malaria parasite becomes infertile when the transport of heavy metals such as copper and iron is blocked. “With mutations in the genes involved, we saw that the parasite was unable to produce reproductive cells, or only produced infertile cells. This blocks the movement of parasites from the mouse to the mosquito. This also provides potential targets for medication, because it will prevent further spread of the disease."
Read more:
Malaria parasite is dependent on heavy metals
Source: Alpha Galileo
The important finding is that the malaria parasite becomes infertile when the transport of heavy metals such as copper and iron is blocked. “With mutations in the genes involved, we saw that the parasite was unable to produce reproductive cells, or only produced infertile cells. This blocks the movement of parasites from the mouse to the mosquito. This also provides potential targets for medication, because it will prevent further spread of the disease."
Read more:
Malaria parasite is dependent on heavy metals
Source: Alpha Galileo
Challenges in point-of-care testing
Utilising POCT is growing rapidly in many countries. When executed with high quality and based on medical needs, POCT gives immediate benefits for the patient and generally speeds up the treatment process. Join the POCT session to share the latest Nordic developments and be inspired by the best practices in Switzerland and Australia. The program also highlights external quality assessment, data management and current standards used in POCT accreditation.
Image: Drahomira Springer
10:00 a.m. - 10:30 a.m.
POCT for glucose measurements in different matrix – reference systems can provide solutions for improved analytical qualityGerhard Schumann, Professor, Dr
Hannover Faculty of Medicine, Institute of Clinical Chemistry, Hannover, Germany
10:30 a.m. - 11:00 a.m.
POCT in Switzerland
Roman Fried, Ph.D., MBA
Institute of Clinical Chemistry, University hospital of Zürich, Switzerland
11:30 a.m. - 12:00 p.m.
Challenges in POCT for coagulation
Piet Meijer, Ph.D.
The ECAT Foundation, Voorschoten, The Netherlands
12:00 p.m. - 12:30 p.m.
POCT accreditation based on ISO standards 15189 and 22870 in Germany
Ralf Bauerndistel, Dr., Lead Assessor
German Accreditation Body (DAkkS), Germany
2:00 p.m. - 2:30 p.m.
POCT data management & connectivity
Klaus Kjøller, Radiometer, Denmark
2:30 p.m. - 3:00 p.m.
EQA of POCT methods: how to interpret results?
Anne Stavelin, Ph.D.
NOKLUS, Bergen, Norway
3:00 p.m. - 3.30 p.m.
POCT – the Australian experience
Tony Badrick, Ph.D. Chief Executive
RCPAQAP, Australia
Read more:
Challenges in point-of-care testing
Nordic Congress on Quality in Laboratory Medicine 11th and 12th of February, 2016, Helsinki
Fridays program on February 12th deals with POCT issues. There are seven interesting lectures and world class speakers to share the most recent studies and trends in POCT.
Image: Drahomira Springer
Scientific Program on Friday 12th of February, 2016
10:00 a.m. - 10:30 a.m.
POCT for glucose measurements in different matrix – reference systems can provide solutions for improved analytical qualityGerhard Schumann, Professor, Dr
Hannover Faculty of Medicine, Institute of Clinical Chemistry, Hannover, Germany
10:30 a.m. - 11:00 a.m.
POCT in Switzerland
Roman Fried, Ph.D., MBA
Institute of Clinical Chemistry, University hospital of Zürich, Switzerland
11:30 a.m. - 12:00 p.m.
Challenges in POCT for coagulation
Piet Meijer, Ph.D.
The ECAT Foundation, Voorschoten, The Netherlands
12:00 p.m. - 12:30 p.m.
POCT accreditation based on ISO standards 15189 and 22870 in Germany
Ralf Bauerndistel, Dr., Lead Assessor
German Accreditation Body (DAkkS), Germany
2:00 p.m. - 2:30 p.m.
POCT data management & connectivity
Klaus Kjøller, Radiometer, Denmark
2:30 p.m. - 3:00 p.m.
EQA of POCT methods: how to interpret results?
Anne Stavelin, Ph.D.
NOKLUS, Bergen, Norway
3:00 p.m. - 3.30 p.m.
POCT – the Australian experience
Tony Badrick, Ph.D. Chief Executive
RCPAQAP, Australia
Read more:
Challenges in point-of-care testing
Welcome to Helsinki!
Source: Labquality
How to detect and preserve human stem cells in the lab
Human stem cells that are capable of becoming any other kind of cell in the body have previously only been acquired and cultivated with difficulty. Scientists at the Max Delbrück Center for Molecular Medicine (MDC) in the Helmholtz Association have now presented details of a method to detect such pluripotent cells in a cell culture and preserve them in the laboratory.
The researchers had already presented their methodological principles in late 2014 in the scientific journal Nature (doi: 10.1038/nature13804). At that time, they had located a sequence named HERVH, which is active in the genetic material of naive stem cells. Using a reporter, which they had linked to a fluorescent protein, the researchers were able to maintain HERVH in an active state and simultaneously detect the cells that had retained pluripotency.
Read more:
How to detect and preserve human stem cells in the lab
Source: EurekAlert! Science News
The researchers had already presented their methodological principles in late 2014 in the scientific journal Nature (doi: 10.1038/nature13804). At that time, they had located a sequence named HERVH, which is active in the genetic material of naive stem cells. Using a reporter, which they had linked to a fluorescent protein, the researchers were able to maintain HERVH in an active state and simultaneously detect the cells that had retained pluripotency.
Read more:
How to detect and preserve human stem cells in the lab
Wednesday, January 20, 2016
hCGβcf in Urine
The Pregnancy lab has blogged previously about false negative results in qualitative point-of-care (POC) hCG devices due to high concentrations of hCGβcf in urine. It is shown that the majority of qualitative POC hCG devices are actually susceptible to false negative results due to saturation of capture antibodies by high concentrations of hCGβcf. These findings have led to an increased interest in urine hCGβcf measurements.
However, only a few research laboratories quantify hCGβcf, so it is difficult for most clinical laboratories to determine which urine samples have high concentrations of this hCG variant.
Read more:
An Easy Way to Estimate hCGβcf Concentration in Urine
Source: The Pregnancy Lab
However, only a few research laboratories quantify hCGβcf, so it is difficult for most clinical laboratories to determine which urine samples have high concentrations of this hCG variant.
Read more:
An Easy Way to Estimate hCGβcf Concentration in Urine
Source: The Pregnancy Lab
Tuesday, January 19, 2016
Unmet clinical needs in cervical cancer screening
The incidence of cervical cancer has dropped dramatically due to the success of the Papanicolaou (Pap) test, (the cytologic examination of cervical cells) in the detection of high-grade premalignant lesions that can be treated before they progress to invasive cervical carcinoma. Although the Pap test is the most effective tool ever deployed for cancer screening, it has been limited by problems of low sensitivity for high-grade premalignant lesions of the cervical mucosa.
Epidemiologic and molecular studies over the past three decades have firmly established that human papillomavirus (HPV) infection is the etiologic agent for virtually all cases of cervical squamous cell carcinoma (SCC) and also for the vast majority of cases of endocervical adenocarcinoma. Although the development of HPV-based test strategies can be used to enhance sensitivity for the detection of clinically significant lesions, HPV testing has been less effective as a primary screening assay in patient populations that have a high prevalence of HPV infection, including adult women under age 30 in both industrialized nations and many third-world countries. In addition, the incidence of death due to cervical cancer has not changed in many developing countries due to difficulties in introducing cost-effective and highly sensitive and specific cervical cancer screening programs that do not require a large clinical laboratory infrastructure and trained cytotechnologists to analyze results. Hence, there is a significant need for a new generation of molecular tests that can augment the existing Pap test, and potentially replace the HPV or Pap tests as the frontline screen in developing countries.
Read more:
Unmet clinical needs in cervical cancer screening
Source: MLO
Image credits: icytology
Epidemiologic and molecular studies over the past three decades have firmly established that human papillomavirus (HPV) infection is the etiologic agent for virtually all cases of cervical squamous cell carcinoma (SCC) and also for the vast majority of cases of endocervical adenocarcinoma. Although the development of HPV-based test strategies can be used to enhance sensitivity for the detection of clinically significant lesions, HPV testing has been less effective as a primary screening assay in patient populations that have a high prevalence of HPV infection, including adult women under age 30 in both industrialized nations and many third-world countries. In addition, the incidence of death due to cervical cancer has not changed in many developing countries due to difficulties in introducing cost-effective and highly sensitive and specific cervical cancer screening programs that do not require a large clinical laboratory infrastructure and trained cytotechnologists to analyze results. Hence, there is a significant need for a new generation of molecular tests that can augment the existing Pap test, and potentially replace the HPV or Pap tests as the frontline screen in developing countries.
Read more:
Unmet clinical needs in cervical cancer screening
Source: MLO
Image credits: icytology
Monday, January 18, 2016
Pre-kallikrein associated with the vascular complications in type 1 diabetes
Researchers from the Medical University of South Carolina (MUSC), the American University of Beirut (AUB), and Case Western Reserve University report that a molecule called pre-kallikrein (PK) could be a target for the vascular complications associated with type 1 diabetes.
The study focused on levels of PK in blood samples paired with ultrasounds taken to measure the thickness of the intima-media of their carotid arteries. Relevance was found: patients with higher levels of PK in their blood do have thicker layers of intima-media in the vasculature of their carotids.
Read more:
Plasma marker of vascular disease confirmed in type 1 diabetes patients
Source: Eurek Alert
The study focused on levels of PK in blood samples paired with ultrasounds taken to measure the thickness of the intima-media of their carotid arteries. Relevance was found: patients with higher levels of PK in their blood do have thicker layers of intima-media in the vasculature of their carotids.
Read more:
Plasma marker of vascular disease confirmed in type 1 diabetes patients
Source: Eurek Alert
Sunday, January 17, 2016
120 Days of Love
The love story of this red cell lasts around four months
Human red blood cells (RBC), after differentiating from erythroblasts in the bone marrow, are released into the blood and survive in the circulation for approximately 115 days. In humans and some other species, RBC normally survive in a nonrandom manner. This means that all of the RBC in an age cohort are removed by the reticuloendothelial system at about the same time. In practice there is considerable variation in the lifespan of human RBC. In a normal individual with a mean RBC lifespan of 115 days, this value may vary between 70 and 140 days. Among individuals the mean lifespan varies by approximately ±15%.
Read more:
Measurement of Red Cell Lifespan and Aging
Source: NCBI
Image credits: Trent McCallum
Human red blood cells (RBC), after differentiating from erythroblasts in the bone marrow, are released into the blood and survive in the circulation for approximately 115 days. In humans and some other species, RBC normally survive in a nonrandom manner. This means that all of the RBC in an age cohort are removed by the reticuloendothelial system at about the same time. In practice there is considerable variation in the lifespan of human RBC. In a normal individual with a mean RBC lifespan of 115 days, this value may vary between 70 and 140 days. Among individuals the mean lifespan varies by approximately ±15%.
Read more:
Measurement of Red Cell Lifespan and Aging
Source: NCBI
Image credits: Trent McCallum
Epigenetics Research Reveals a Range of Clinical Possibilities
Modern efforts toward explaining human disease purely based upon sequencing cannot possibly succeed in isolation,” says Andrew P. Feinberg, M.D., professor of medicine and director of the Center for Epigenetics at Johns Hopkins University School of Medicine. “At least half of human disease is caused by exposure to the environment.”
While the contribution of genetic factors to disease is more predictable and easier to study in the case of highly penetrant Mendelian disorders, most medical conditions involve multiple genes that may interact with one another and with environmental factors. Particularly for these conditions, capturing epigenetic changes becomes a crucial aspect of understanding pathogenesis and designing prophylactic and therapeutic interventions.
In a recent study, Dr. Feinberg and colleagues reported that large blocks of the human genome are hypomethylated in the epidermis as a result of sun exposure, which together with aging represents a known risk factor for skin cancer. These hypomethylated regions overlap with regions that have methylation changes in patients with squamous cell carcinoma.
Read more:
Epigenetics Research Reveals a Range of Clinical Possibilities
Source: GEN
While the contribution of genetic factors to disease is more predictable and easier to study in the case of highly penetrant Mendelian disorders, most medical conditions involve multiple genes that may interact with one another and with environmental factors. Particularly for these conditions, capturing epigenetic changes becomes a crucial aspect of understanding pathogenesis and designing prophylactic and therapeutic interventions.
In a recent study, Dr. Feinberg and colleagues reported that large blocks of the human genome are hypomethylated in the epidermis as a result of sun exposure, which together with aging represents a known risk factor for skin cancer. These hypomethylated regions overlap with regions that have methylation changes in patients with squamous cell carcinoma.
Read more:
Epigenetics Research Reveals a Range of Clinical Possibilities
Source: GEN
Is privacy possible in the post-genomic era?
Privacy is a fanciful delusion in the post-genomic era, or so said Christopher Mason during a consumer genomics panel at this week’s J.P. Morgan Healthcare Conference.
“I think privacy is going to be really hard to keep, unless you walk around in a hermetically sealed plastic suit,” said Mason, an assistant professor of computational genomics at Weill Cornell Medical College. “You lose cells wherever you walk.”
As a case in point, he gestured to the audience at JPM – and said if everyone left the room, and their DNA was sequenced simply from the genetic material they left behind on the seats, the results would be highly revelatory.
Read more:
Privacy in the post-genomic era: Impossible.
Source: MedCityNews
“I think privacy is going to be really hard to keep, unless you walk around in a hermetically sealed plastic suit,” said Mason, an assistant professor of computational genomics at Weill Cornell Medical College. “You lose cells wherever you walk.”
As a case in point, he gestured to the audience at JPM – and said if everyone left the room, and their DNA was sequenced simply from the genetic material they left behind on the seats, the results would be highly revelatory.
Read more:
Privacy in the post-genomic era: Impossible.
Source: MedCityNews
Saturday, January 16, 2016
NT-proBNP and Cardiac Troponin T for CVD Risk Assessment
N-terminal-pro–B-type natriuretic peptide (NT-proBNP) and cardiac troponin T (TnT) predict cardiovascular disease (CVD) risk in a variety of populations. Whether their predictive value varies by ethnicity is unknown. We sought to determine whether NT-proBNP and TnT improve prediction of incident coronary heart disease (CHD) and CVD, independent of CVD risk factors, in a multiethnic population; whether NT-proBNP improves prediction compared with the Framingham Risk Score or the Pooled Cohort Risk Equation; and whether a second NT-proBNP further improves prediction.
N-terminal-pro–B-type natriuretic peptide improved risk prediction and classification compared with the Framingham Risk Score and the Pooled Cohort Risk Equation. Change in NT-proBNP was independently associated with events. None of the observed associations varied by ethnicity.
Both NT-proBNP and TnT are predictors of incident CHD, independent of established risk factors and ethnicity, in a multiethnic population without known CVD. Change in NT-proBNP may add additional prognostic information.
Read more:
NT-proBNP and Cardiac Troponin T for CVD Risk Assessment
Source: Medscape
Image credits: Nature Clinical Practice
N-terminal-pro–B-type natriuretic peptide improved risk prediction and classification compared with the Framingham Risk Score and the Pooled Cohort Risk Equation. Change in NT-proBNP was independently associated with events. None of the observed associations varied by ethnicity.
Both NT-proBNP and TnT are predictors of incident CHD, independent of established risk factors and ethnicity, in a multiethnic population without known CVD. Change in NT-proBNP may add additional prognostic information.
Read more:
NT-proBNP and Cardiac Troponin T for CVD Risk Assessment
Source: MedscapeImage credits: Nature Clinical Practice
Low Blood Bicarbonate Linked to Earlier Death in Healthy Older Adults
Generally healthy older individuals with normal or high bicarbonate levels in the blood had a similar risk of dying during follow-up, but patients with low bicarbonate had a 24% increased risk compared with these groups.
Low blood levels of bicarbonate may indicate an elevated risk of premature death in generally healthy older individuals, according to a study appearing in an upcoming issue of the Clinical Journal of the American Society of Nephrology (CJASN). The findings suggest that the blood marker is an important health indicator and that future studies should examine the potential of increasing bicarbonate levels to prolong life.
The findings suggest that blood bicarbonate concentrations, which are commonly measured, may help clinicians identify people at elevated risk of premature death. In people with low bicarbonate levels, some may benefit from increasing intake of foods that produce bicarbonate in the body, such as fruits and vegetables.
Read more:
Low Blood Levels of Bicarbonate Linked to Earlier Death in Healthy Older Adults
Source: News Wise
Low blood levels of bicarbonate may indicate an elevated risk of premature death in generally healthy older individuals, according to a study appearing in an upcoming issue of the Clinical Journal of the American Society of Nephrology (CJASN). The findings suggest that the blood marker is an important health indicator and that future studies should examine the potential of increasing bicarbonate levels to prolong life.
The findings suggest that blood bicarbonate concentrations, which are commonly measured, may help clinicians identify people at elevated risk of premature death. In people with low bicarbonate levels, some may benefit from increasing intake of foods that produce bicarbonate in the body, such as fruits and vegetables.
Read more:
Low Blood Levels of Bicarbonate Linked to Earlier Death in Healthy Older Adults
Source: News Wise